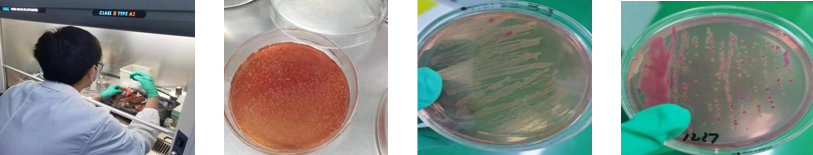
1761206355821850.png

|
Phage Therapy in Poultry: Case Studies and How It Works
Across modern poultry production, bacterial diseases such as Salmonella and E. coli remain persistent threats to flock health, productivity, and food safety. Antibiotic resistance, market pressure for residue-free products, and regulatory oversight on drug residues have pushed producers to seek alternatives that act quickly and safely. This is where phage therapy in poultry—targeted bacteriophage-based control—enters as a science-backed, residue-free option that can be integrated into daily farm operations without disrupting production. This article focuses on information rather than promotion: what phage therapy in poultry is, when and how it works, evidence from real farms, and practical implementation steps. We also share lessons learned from actual outbreaks where targeted phage solutions restored flock health within days, even when antibiotics had failed. What is phage therapy in poultry?
Bacteriophages (phages) are naturally occurring viruses that infect and kill bacteria. Their action is highly specific—phages seek out particular bacterial hosts, attach to receptors on the cell surface, inject their genetic material, replicate inside the bacterium, and then lyse (burst) the cell, releasing many progeny phages that continue the cycle. In poultry applications, phage therapy in poultry targets key pathogens like Salmonella and E. coli without harming birds or leaving residues in eggs and meat. Because phages are host-specific, they leave beneficial microflora largely intact and reduce selection pressure for resistance compared to broad-spectrum antibiotics. Phage therapy in poultry is also compatible with vaccination, biosecurity, water acidification, and herbal support programs, making it a strong component in integrated health management. Why farmers consider phage therapy in poultry
Common bacterial challenges in poultrySalmonella: In breeders and layers, Salmonellosis can cause depression, ruffled feathers, yellowish-white or greenish diarrhea, reduced feed intake, and increased mortality. Necropsy findings often include bronze or greenish-brown livers with gray-white necrotic foci, splenomegaly, fibrinous exudates on the liver, and liquefied ovarian follicles. E. coli: Colibacillosis typically presents with depression, pale combs, decreased feed intake, and diarrhea. Necropsy can reveal fibrinous perihepatitis/pericarditis, enlarged livers with yellow fibrin, and variable white necrotic spots. Mixed infections and stress-related immunosuppression frequently exacerbate severity. Real-world case studies: Phage therapy in poultry in actionCase Study 1: Salmonella outbreak in a breeder flock (Muping, Shandong)
Farm profile: 20,000 breeder chickens, 40 weeks of age. Problem: High mortality unresponsive to antibiotics (e.g., florfenicol). Birds were depressed, lethargic, with pasty white feces; necropsy showed enlarged livers with white necrotic spots; spleens were swollen and hemorrhagic. Diagnosis: Salmonellosis, confirmed by isolating four Salmonella strains from samples. Phage protocol: JIN-SHA powder (Salmonella phage). Dosage: one 100 g bag per 10,000 birds via concentrated drinking water over 2–4 hours, for three consecutive days. Outcome:
Case Study 2: Salmonella outbreak in a large layer farm (Jiaozhou, Shandong)
Farm profile: 300,000 Hy-Line Browns, 50,000 birds per house; birds around 200 days old. Problem: Depression and reduced feed intake at day 200; daily mortality exceeded 30 birds in one house by day 210; yellowish-green and white diarrhea with vent staining. Necropsy: Bronze liver with fibrinous exudate; liquefied ovarian follicles. Diagnosis: Salmonellosis, confirmed by isolating five Salmonella strains. Phage protocol: JIN-SHA powder, one 100 g bag per 10,000 birds via concentrated drinking water for 2–4 hours, repeated for three days. Outcome:
Case Study 3: Salmonella outbreak and long-term control in layers (Hebei)
Farm profile: 60,000 Hy-Line Browns, 10,000 per house; birds around 190 days old. Problem: Sudden onset mortality, later drop in egg production; daily deaths >30 birds; lethargy, yellowish-green diarrhea, ruffled feathers, pale combs. Necropsy: Enlarged, brittle livers with gray-white necrotic spots; some livers greenish-brown/bronze; liquefied ovarian follicles. Diagnosis: Salmonellosis, confirmed by isolating four Salmonella strains. Phage protocol: JIN-SHA powder, one 100 g bag per 10,000 birds via concentrated water for 2–4 hours, three days. Outcome:
Case Study 4: E. coli outbreak in breeders (Yantai, Shandong)
Farm profile: 30,000 breeder chickens, 45 weeks of age. Problem: Ten days of antibiotics (Amoxicillin, Dimetridazole) failed; average daily mortality ~90 birds; depression, reduced feed intake, pale combs, yellowish-white diarrhea. Necropsy: Fibrinous perihepatitis and pericarditis; enlarged livers with yellow fibrinous exudate; variable white necrotic spots. Diagnosis: E. coli infection, confirmed by isolating six E. coli strains. Phage protocol: JIN-DA powder (E. coli phage), one 500 g bag per 10,000 birds via concentrated drinking water over 2–4 hours, for three consecutive days. Outcome:
Practical implementation: How to use phage therapy in poultry
Safety, residues, and spectrum considerations
Phage therapy in poultry is host-specific and residue-free. It targets Salmonella or E. coli without leaving drug residues in meat or eggs, aligning with residue testing programs in many markets. Our phage powders are ultrafiltered, leaving minimal residual culture media, and are verified through in-house quality control for safety and efficacy. Withdrawal period is effectively nil under practical use. The “cocktail” design broadens coverage. Our Salmonella phage contains 12–14 phage strains chosen for a wide lytic spectrum across common field isolates, while the E. coli phage typically includes 12–16 strains to increase coverage for the more diverse, strain-specific nature of E. coli. This approach maximizes the probability of rapid bacterial clearance during outbreaks. Understanding differences between Salmonella and E. coli phages
How phage therapy in poultry fits into integrated health managementPhage therapy in poultry is not a silver bullet; it is a precision tool for bacterial control within a broader program:
If you face recurring Salmonella or E. coli challenges, or if antibiotics are underperforming due to resistance or residue concerns, consider integrating phage therapy in poultry into your health plan. |